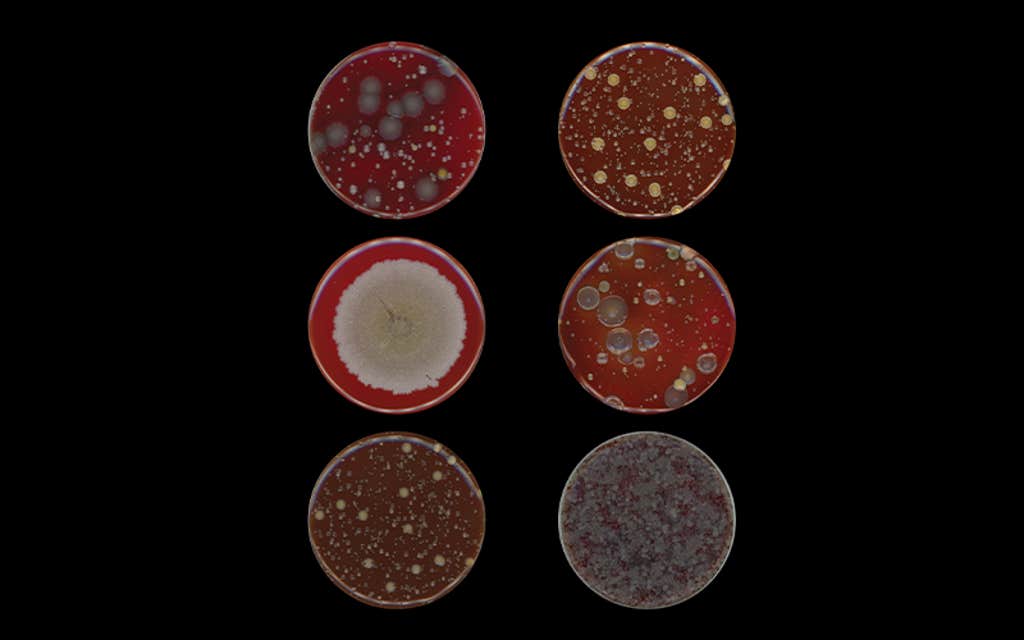
In Body Image
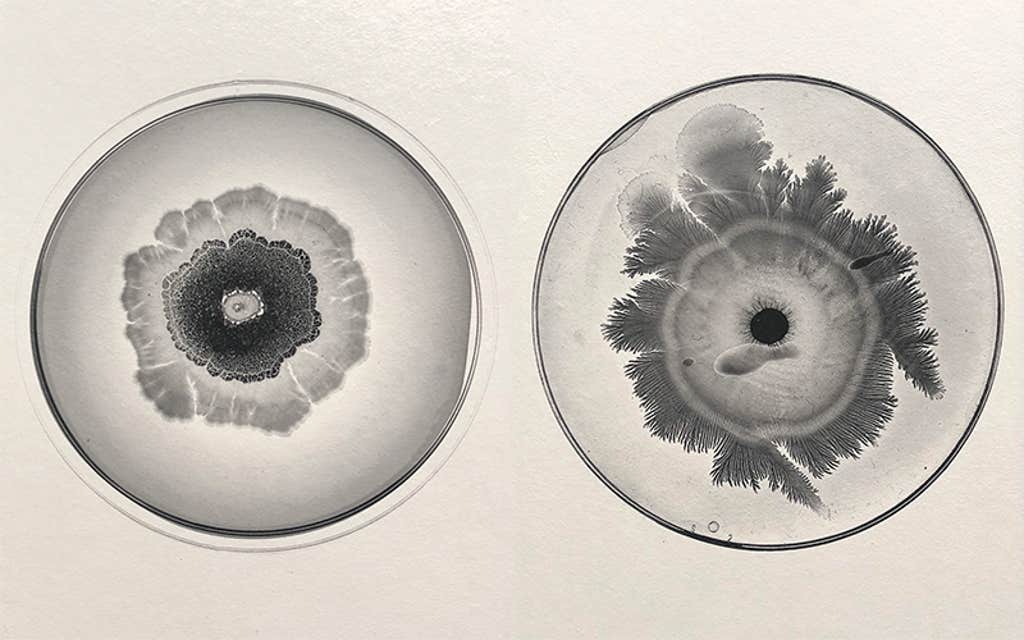
In Body Image

Aesthetic bewilderment” is a kind of common ground in science and art, an engine for new ideas in both disciplines, writes Brazilian artist Vik Muniz in the introduction to a new book of photographs and essays about bacteria by microbiologist Tal Danino. That book, titled Beautiful Bacteria: Encounters in the Microuniverse, was published last week.
Danino collaborated with Muniz on a number of projects—including one that involved making art out of viruses and cancer cells—when Muniz was a visiting artist at MIT. “I think that scientists oftentimes see a beautiful pattern and wonder about the underlying processes that make such a pattern happen,” says Danino when I ask him what aesthetic bewilderment means to him. Take the complex architectures of the snowflake, the markings on the coats of animals, or the fractal-like arrangements produced by some communities of microbes. “I think that there’s a lot of scientific work that just begins with a scientist saying, ‘Wow, this is such a cool pattern or dynamic process and I really want to study it,’” he says.
The microbes themselves are collaborators in the artwork process.
Aesthetic bewilderment seems like the bedrock of Danino’s new book: Here are the invisible microworlds so many of us take for granted brought to screaming life in flamboyant colors and electrifying geometries. Bacteria often inspire fear or disgust—particularly disease-causing pathogens such as Escherichia coli or Staphylococcus—but the beauty of these images draws the attention, provokes a desire to understand what the eye beholds.
We spoke with Tal Danino about the book, bacteria, and his work.
Do you remember the first time you found bacteria beautiful?
My dad is an engineer and my mom has an artistic background so I was always doing some art and some engineering. In grad school, these two disciplines converged. I was looking at microbes under the microscope and designing them to communicate with one another as a population, what people call core sensing, and turning what I saw into these beautiful movies. The microscope would take a picture every minute, we would stitch it together and make a movie over time and speed it up. These films were rhythmic, making oscillations, waves, all these really interesting patterns. At the time I was doing a lot of science outreach, so showing videos like this to kids and to general audiences, non-scientists. I was thinking about how do we share the excitement of the research that we’re doing, the excitement of discovery, and the really beautiful things that scientists see on a daily basis.
Do you think there’s something inherently beautiful about bacteria?
I think that the thing about bacteria that is unique in the bioart realm is that the microbes themselves are collaborators in the artwork process. We put them in specific conditions inside a petri dish, or we genetically manipulate them, so we give them a set of instructions. But they have their own minds, so to speak, and they make these beautiful patterns that are inherently one-of-a-kind. Any of the dishes that you see in the book, I can’t make them again. It’s impossible. There’s a lot of unpredictability and chaos because they have these elements of noise and randomness and mutation and adaptation, which are in some ways like intelligent features of those systems. It’s exciting to see what happens and it’s different every time.
You write in the book that there are trillions of bacteria in our bodies, and that’s more than there are stars in the galaxy, which is kind of difficult to comprehend and even a little frightening. What should we make of that and what does it tell us about life on this planet?
It’s almost like a philosophical challenge when you hear something like that because it makes you turn inward. We’ve done so much space exploration, and we’re always looking to new parts of the galaxies. This is a very popular theme in contemporary culture today. But it’s really interesting to think about how even within us—within one single person—there’s just enormous complexity. And that’s the complexity that’s not just in our own DNA, but rather this other part of our body, which is transportable and manipulatable and has this interesting evolutionary history. These bacteria evolved with us.
You mention that those working at the frontiers of research in microbiology are forging new kinds of relationships between humans and microbes and machines, including using AI to imagine new forms of bacteria. Can you tell me about the aims of this work?
Bacteria in our bodies know how to sense thousands of different molecules, so in my own work, we have engineered them as biosensors to detect pathological diseases like cancers. We program their DNA. But that has pros and cons. Another approach is to have bacteria communicate with electronic devices. So one group devised a pill into which you could insert bacteria that could communicate with a small electronic interface. The researchers gave this pill to pigs and rodents and showed that the pill could travel through the GI tract and the bacteria could sense molecules that are important in gut inflammation and then create electrical signals that would be communicated by the device to a cell phone for detection. So there are some really interesting bacteria-machine connections happening now.

I think the role of artificial intelligence is twofold: One, to better understand a lot of the data that’s coming out and to be able to predict how to better design these microbial systems. And in the future also to help us try to interface with our bacterial systems to say, “Hey, I wanna design a bacteria that does X, Y, and Z. Can you design the DNA sequence that does this?” AI would help you learn that process so that you could build it in the lab, or a robot could build it for you. These kinds of concepts are really in their infancy.
What is one of the biggest mysteries about bacteria that scientists are still trying to solve?
The really big question is how do the bacteria in our bodies affect our health and disease? You may have heard about the importance of the microbiome, but the challenge is that a lot of the existing studies are correlational. Certain bacteria species are more prevalent in cancer patients, but it’s not clear that they necessarily cause the cancer. And the causal studies are oftentimes done in mice, which are pretty different in terms of host-microbe interactions. So the microbiome has become such a huge field because of its complexity and we are trying to understand how so many of these strains affect different points of health and disease.

In my own work, a huge open question is, how do you best design a microbe to treat a disease like cancer? We work on these bacteria that can get into tumors, kind of like Trojan horses, and make drugs. And there’s so many things you can do. You can choose different types of bacteria, you can choose different types of drugs, you can make them safer and more specific, and you can choose different kinds of cancers. And so it’s all about finding the right combination of elements.
Is there anything else you want readers to take away from this book?
I think one of the things that is important to know is that the book focuses on the Petri dish, which is a really simple and accessible platform for looking at bacteria. And all the imaging that we do is with a commercial scanner you could buy or a camera, and a lot of our swabs were done at home. So we are using very accessible technologies that other people could also use, science or art students or anybody who wants to make bacteria art. In the scientific literature, you won’t often find Petri dish images where the focus is their aesthetics. We really focus on the aesthetics and these very simple tools that might inspire some others to do this kind of work or become interested in microbiology.
All images and captions by Tal Danino.